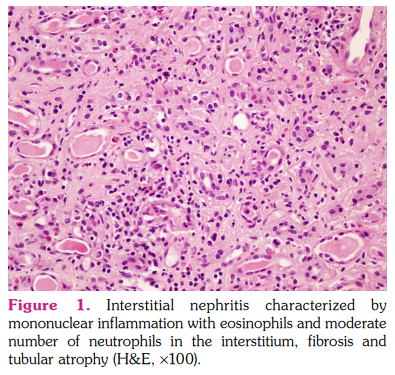

Tubulointerstitial nephritis (TIN) and uveitis (TINU) syndrome is an uncommon disease mainly identified by two entities specified in its name: TIN and uveitis.[1,2] According to Mandeville et al.’s[2] diagnostic criteria, definitive diagnosis should be established with renal biopsy and ophthalmologic examination after possible differential diagnoses are excluded.
A 55-year-old female patient was referred to our rheumatology clinic for evaluation of dry eyes and malaise. In the first evaluation, the patient reported dry eyes and mouth and had a history of idiopathic unilateral anterior uveitis. After seeing an increased creatinine level (2.64 mg/dL), we consulted the case with the nephrology unit. As a part of nephrology examination, 24-h urine collection revealed 848 mg proteinuria per day. In addition, 1+ erythrocyte was detected in a spot urine test with seven leukocytes and five erythrocytes per high-power field of the urine sediment. Urine culture was sterile. Normal anion gap acidosis was detected in blood gas analysis (pH: 7.22, bicarbonate: 16.6, and anion gap: 7). C-reactive protein (CRP) level was 109.7 mg/L. Other laboratory results are shown in Table 1. Ophthalmologic examination revealed anterior uveitis. The Schirmer test (3 mm in the right eye and 0 mm in the left eye) and tear break-up time test (5 sec in the right eye and 3 sec in the left eye) confirmed dryness in both eyes. Antinuclear antibody screen by indirect immunofluorescence technique showed a homogenous nuclear pattern with 1:160 titer.
Rheumatologic findings, proteinuria, and increasing creatinine levels necessitated a renal biopsy, which revealed TIN with prominent eosinophilic infiltration in both cortical and medullary interstitium (Figure 1). Furthermore, a salivary gland biopsy was performed, which did not show any specific findings. Anti-SSA and anti-SSB were negative in the extractable nuclear antigen panel. After ruling out differential diagnoses, TINU syndrome was diagnosed.
We commenced prednisolone with a dose of 0.5 mg/kg/day. Erythrocyte sedimentation rate normalized after two weeks of treatment, and the creatinine levels dropped. Uveitis went into remission. The steroid dose was tapered, and the patient completed the therapy in a total of eight weeks. As a maintenance therapy, mycophenolic acid 500 mg twice daily was prescribed. Subsequently, ongoing improvement in creatinine and CRP levels were observed. The patient is still under follow-up, and the most recent laboratory results showed creatinine and CRP levels of 1.23 mg/dL and 2.71 mg/L, respectively.
This case demonstrated an uncommon clinical presentation compared to other reported TINU cases due to sicca symptoms. In the literature, dryness has been described as a rare symptom and is only seen in 3% of patients.[2] To the best of our knowledge, there is only one reported case in which a patient presented with sicca symptoms and was diagnosed with TINU syndrome.[3]
In the diagnostic approach to TINU syndrome, exclusion of diseases such as sarcoidosis and Sjögren’s disease is necessary since oculorenal involvement might be seen in the course of these diseases.[4] Although Sjögren’s disease might be suspected in this 55-year-old female patient with sicca symptoms,[5] salivary gland biopsy findings and the extractable nuclear antigen panel were not compatible with Sjögren’s disease. Additionally, as there was no granuloma formation in the kidney biopsy, TIN could not be attributed to sarcoidosis or Sjögren's disease. Furthermore, there was no hypercalcemia or hypercalciuria that would suggest sarcoidosis. Moreover, fluorodeoxyglucose-positron emission tomography also did not show any specific findings and ruled out sarcoidosis. Besides, the patient didn’t have any respiratory symptoms. Negative direct immunofluorescence and normal serum complement levels helped rule out lupus nephritis and immunoglobulin G4-related TIN. Antiphospholipid anti-double stranded DNA and anti-Smith antibodies were also negative, and the patient did not have any neuropsychiatric, mucocutaneous, serosal, or musculoskeletal symptoms. Therefore, the patient did not fulfill the 2019 EULAR (European Alliance of Associations for Rheumatology)/ACR (American College of Rheumatology) systemic lupus erythematosus classification criteria. Drug-related interstitial nephritis was also unlikely as there were no drugs that were commenced or stopped during the diagnosis and follow-up period.
In conclusion, this reported TINU case with an overlap of symptoms with Sjögren’s disease underlines that TINU might have different clinical features. This report points out a new perspective on approaches in uncommon clinical presentations of patients with oculorenal involvement.